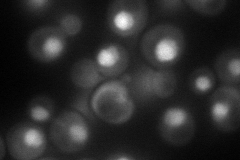
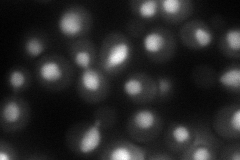
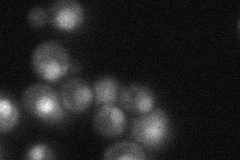

View description
Karyopherin involved in nuclear import and export of proteins, including import of replication protein A and export of Swi6p, Far1p, and Pho4p; required for re-export of mature tRNAs after their retrograde import from the cytoplasm
Localization:
Intensity:
Fold change:
Significance:
-
C’ GFP library in SD

nucleus41.14 -
N' NOP1pr-GFP in SD
nucleus93.5543 -
N' TEF2pr-mCherry in SD
nucleus99.6273 -
N' NATIVEpr-GFP in SD
below threshold39.4401 -
N' TEF2pr-VC and Cyto-VN in SD

#N/A0 -
C’ GFP library in SD+DTT

nucleus44.991.09No -
C’ GFP library in SD+H2O2

nucleus41.411No -
C’ GFP library in Starvation Media

nucleus41.411No -
C’ GFP library on the background of Pup2-DaMP

nucleus -
C’ GFP library on the background of CCT mutant

nucleus35.11660.853443No
